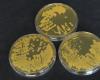

[ММСО] ММСОНУ, ЛчШИРћАцСІ СЖСї РЬТїКИРќ СіПјЁЎИТМеЁЏ |2021. 02.02 [ММСО] ММСОНУ, ЛчШИРћАцСІ СЖСї РЬТїКИРќ СіПјЁЎИТМеЁЏ |2021. 02.02
[ММСО/CTN]СЄЙЮСи БтРкЄгММСОЦЏКАРкФЁНУ(НУРх РЬУсШё)ПЭ НХПыКИСѕБтБн(УцУЛПЕОїКЛКЮРх ЧбПЕТљ), ЧЯГЊРКЧр(УцУЛПЕОїБзЗь УбА§ДыЧЅ РБМјБт)РЬ 2РЯ НУУЛ СЂАпНЧПЁМ ЁЎММСОНУ ЛчШИРћАцСІ СЖСїРЛ РЇЧб БнРЖСіПј ОїЙЋЧљОрЁЏРЛ УМАсЧпДй.
РЬЙј ЧљОрРК ЛчШИРћ АЁФЁИІ НЧЧіЧЯДТ ЛчШИРћАцСІ СЖСїПЁ ДыЧб РЬТїКИРќ СіПјРИЗЮ РкБн СЖДоРЬ ОюЗСПю БтОїРЧ ЁІ |
|
 [БГРА] ЛчУЕБГРАСіПјУЛ, МвЛѓАјРЮ ПЉЗЏКа РРПјЧеДЯДй. |2021. 02.02 [БГРА] ЛчУЕБГРАСіПјУЛ, МвЛѓАјРЮ ПЉЗЏКа РРПјЧеДЯДй. |2021. 02.02
[БГРА/CTN]ЙцЙЬШё БтРк = ЛчУЕБГРАСіПјУЛ(БГРАРх БшЙ§Ая)РК ФкЗЮГЊ19РЧ РхБтШЗЮ РЮЧи ОюЗСПђРЛ АоАэ РжДТ МвЛѓАјРЮЕщРЛ ЕНБт РЇЧи 'ТјЧб МБ(рЛ) АсСІ ФЗЦфРЮ'ПЁ ЕПТќЧпДй.
РЬ ФЗЦфРЮРК БтАќРЧ ОїЙЋУпСјКё ЕюРЛ ШАПыЧи РЮБй МвЛѓАјРЮ ИХРхПЁ РЯСЄОзРЛ ЙЬИЎ АсСІЧб Ек УпШФ ЙцЙЎЧЯПЉ АсСІОзПЁ ДыЧб МКёНКИІ СІАјЙоДТ АЭРЬДй.
БшЙ§Ая БГРАЁІ |
|
 [БГРА] ЛчУЕБГРАСіПјУЛ, УЛЗХРЛ ДйСќЧиПф! УЛЗХРЛ ЙшПіПф! |2021. 02.02 [БГРА] ЛчУЕБГРАСіПјУЛ, УЛЗХРЛ ДйСќЧиПф! УЛЗХРЛ ЙшПіПф! |2021. 02.02
[БГРА/CTN]ЙцЙЬШё БтРк = АцЛѓГВЕЕЛчУЕБГРАСіПјУЛ(БГРАРх БшЙ§Ая)РК СіГ 1РЯ ДыШИРЧНЧПЁМ РќСїПјРЛ ДыЛѓРИЗЮ 2Пљ УЛЗХРЧ ГЏРЛ ПюПЕЧпДй.
РЬГЏ УЛЗХРЧ ГЏПЁДТ Рќ СїПјРЬ ФкЗЮГЊ19 ПЙЙцРЛ РЇЧи АХИЎЕЮБтИІ НЧУЕЧЯИщМ СјЧрЕЦРИИч, УЛЗХНЧУЕРЧСіИІ ШЎАэШї ДйСњ Мі РжДТ АшБтИІ ИЖЗУЧЯАэРк УЛЗХНЧУЕАсРЧМИІ ГЖЕЖЧпДй.
'
ЖЧЧб, ЙЮСЗДыИэР§ЁІ |
|
 [ЕПБИ] ДыРќЕПБИ СжЙЮЛчЖћГзЦЎПіХЉ, УЕЛчРЧ МеБцПЁ ЛчЖћРЧ РтАюММЦЎ БтХЙ |2021. 02.02 [ЕПБИ] ДыРќЕПБИ СжЙЮЛчЖћГзЦЎПіХЉ, УЕЛчРЧ МеБцПЁ ЛчЖћРЧ РтАюММЦЎ БтХЙ |2021. 02.02
[ДыРќ/CTN]СЄЙЮСи БтРкЄгРЬДо 2РЯ ЕПБИ СжЙЮЛчЖћГзЦЎПіХЉ(ДыЧЅ БшСІШЋ)ДТ ФкЗЮГЊ19ЗЮ ОюЗСПю НУБтРгПЁЕЕ КвБИЧЯАэ МГ ИэР§РЛ ИТОЦ ЛчЖћРЧ РтАюММЦЎ 200АГИІ СїСЂ СІРл, ДыРќ ЕПБИ(БИУЛРх ШВРЮШЃ)ПЁ ПРДТ 5РЯ БтХЙНФРЛ АЁСњ ПЙСЄРЬДй.
РЬГЏ ЕПБИ СжЙЮЛчЖћГзЦЎПіХЉ ЛчЙЋНЧ РтАюММЦЎ СІРл ЧіРхПЁ ШВРЮШЃ ЕПБИУЛРхРЬ ТќМЎЧЯПЉ ШИПј Йз РкПјКРЛчЕщЁІ |
|
 [ДыРќ] ДыРќ ЕПБИ, ЁЎСіПЊЙцПЊ РЯРкИЎЛчОїЁЏ КЛАн УпСј |2021. 02.02 [ДыРќ] ДыРќ ЕПБИ, ЁЎСіПЊЙцПЊ РЯРкИЎЛчОїЁЏ КЛАн УпСј |2021. 02.02
[ДыРќ/CTN]СЄЙЮСи БтРкЄгЕПБИ(ЕПБИУЛ ШВРЮШЃ)ДТ СіПЊ АјАјРЯРкИЎ ЛчОї ПюПЕРЛ ХыЧЯПЉ ФкЗЮГЊ19 Ею АЈПАКД ШЎЛъ ЙцСі Йз УыОїУыОрАшУў ЕюРЧ АэПы Йз Л§Аш СіПјРЛ РЇЧб ЁЎ2021Гт СіПЊЙцПЊРЯРкИЎЛчОїЁЏ ТќПЉРк 41ИэРЛ МБЙпЧЯАэ 2Пљ 1РЯКЮХЭ КЛАн УпСјЧбДй.
РЬЙј ЛчОїРК ФкЗЮГЊ19ЗЮ ОюЗСПђРЛ АоАэ РжДТ БИЙЮЕщПЁАд РЯРкИЎИІ СІАјЧи Л§ШАОШСЄ Йз РкЁІ |
|
 [УцКЯ] РЬНУСО УцКЯЕЕСіЛч, "УЛСжЕЕНЩАњ УцКЯЕЕ УЖЕЕЧіОШЛчОї" БЙХфБГХыКЮРхАќПЁ АЧРЧ |2021. 02.02 [УцКЯ] РЬНУСО УцКЯЕЕСіЛч, "УЛСжЕЕНЩАњ УцКЯЕЕ УЖЕЕЧіОШЛчОї" БЙХфБГХыКЮРхАќПЁ АЧРЧ |2021. 02.02
[УцКЯ/CTN]ЙкУЖПь БтРк= РЬНУСО УцКЯЕЕСіЛчДТ РЬРхМЗ․КЏРчРЯ․ЕЕСОШЏ․РгШЃМБ БЙШИРЧПј, УжУцСј УЛСжНУРЧШИ РЧРхАњ ЧдВВ 2.2.(Ш) БЙШИПЁМ КЏУЂШь БЙХфБГХыКЮРхАќРЛ ИИГЊ УЛСжЕЕНЩ ХыАњ УцУЛБЧ БЄПЊУЖЕЕ ГыМБРЧ БЙАЁУЖЕЕИСАшШЙ ЙнПЕ Ею УЖЕЕЧіОШРЛ АЧРЧЧпДй.
РЬГЏ РкИЎДТ СЄКЮРЧ СІ4Тї БЙАЁУЖЕЕИСБИУрАшШЙРЧ ШЎСЄРЬ ОѓИЖ ГВЁІ |
|
 [УцКЯ] СЖДоУЛ, ЙЋСЄРќРќПјРхФЁ(UPS) РгДы ЛѓЧА АГЙп |2021. 02.02 [УцКЯ] СЖДоУЛ, ЙЋСЄРќРќПјРхФЁ(UPS) РгДы ЛѓЧА АГЙп |2021. 02.02
[УЛСж/CTN]ЙкЧќХТ БтРк = СЖДоУЛ(УЛРх БшСЄПь)РК СпМвБтОїРЧ АјАјНУРх СјРд СіПјРЛ РЇЧи ЙЋСЄРќРќПјРхФЁПЁ ДыЧб РгДы ЛѓЧАРЛ ГЊЖѓРхХЭ МюЧЮИєРЛ ХыЧи ШЎДы АјБоЧи ГЊАЁБтЗЮ ЧпДй.
ЙЋСЄРќРќПјРхФЁДТ СЄРќ Ею ЕЙЙп ЛѓШВПЁМЕЕ ОШСЄЕШ РќЗТРЛ АјБоЧЯБт РЇЧб РхКёЗЮ, 384ОяПј(18Гт), 401ОяПј(19Гт), 446ОяПј(20Гт) Ею ИХГт АјАјБтАќРЧ МіПфАЁ СѕЁІ |
|
 [УцКЯ] УцКЯАњЧаБтМњЧѕНХПј, ПТХУЦЎ "CBIST 2030 КёРќМБЦїНФ" АГУж |2021. 02.02 [УцКЯ] УцКЯАњЧаБтМњЧѕНХПј, ПТХУЦЎ "CBIST 2030 КёРќМБЦїНФ" АГУж |2021. 02.02
[УцКЯ/CTN]ЙкУЖПь БтРк= УцКЯАњЧаБтМњЧѕНХПј(ПјРх ГыБйШЃ, РЬЧЯ 'УцКЯАњБтПј')РК ICT/SWЛъОї ШЏАц КЏШИІ МБЕЕЧЯБт РЇЧиЁИCBIST 2030 КёРќМБЦїНФЁЙРЛ ПТХУЦЎ ЙцНФРИЗЮ АГУжЧпДйАэ 2РЯ ЙрЧћДй.
КёРќМБЦїНФРК 'РЮАјСіДЩ(AI) ЦЏШБтЙн СЖМКРИЗЮ АњЧаБтМњ МіЕЕ УцКЯ НЧЧі' РЛ СжСІЗЮ 4Ды УпСјАњСІИІ СІНУЧЯИч ЁуРчДм СпРхБт ЙпРќАшШЙ ЙпЧЅ ЁуЁІ |
|
 [ЕПБИ] ДыРќ ЕПБИ, ЁЏПРЕПМБ ДыУЛШЃ КЂВЩБцЁЎ АцАќАГМБЛчОї ТјАј |2021. 02.02 [ЕПБИ] ДыРќ ЕПБИ, ЁЏПРЕПМБ ДыУЛШЃ КЂВЩБцЁЎ АцАќАГМБЛчОї ТјАј |2021. 02.02
[ДыРќ/CTN]СЄЙЮСи БтРкЄгЕПБИ(БИУЛРх ШВРЮШЃ)ДТ ДыУЛШЃ КЂВЩУрСІ ЧіРхРЮ ЁЏПРЕПМБ ДыУЛШЃ КЂВЩБцЁЎ РЯПј АцАќАГМБ ЛчОїРЛ РЬДо 1РЯ ТјАјЧпДйАэ ЙрЧћДй.
РЬЙј АцАќАГМБЛчОїРК ДыУЛШЃ КЂВЩ УрСІРхРЮ НХЛѓЕП Лъ35ЙјСі РЯПјПЁ 1Оя ПјРЧ ЛчОїКёИІ ХѕРдЧи РќИСНКХФЕх, КЅФЁ Ею ШоАдНУМГ МГФЁПЭ ПеКЂГЊЙЋ, ШЋАЁНУ Ею ДйУЄЗЮПю МіИё НФРчЗЮ КЂВЩ УрСІЁІ |
|
 [БЄСжЁЄРќГВ] РхШяБК, КНУЖ ЛъКв ПЙЙцПЁ УбЗТ |2021. 02.02 [БЄСжЁЄРќГВ] РхШяБК, КНУЖ ЛъКв ПЙЙцПЁ УбЗТ |2021. 02.02
[РхШя/CTN]РЬНТШЃ БтРк = РхШяБКРК 2021ГтРЛ ИТОЦ КЛАнРћРЮ ЛъКв ПЙЙц ШАЕПРЛ УпСјЧбДй.
БКРК КНУЖ ЛъКв СЖНЩ БтАЃ(2.1~5.15)РЛ ОеЕЮАэ МБСІРћРЬИщМ ШПАњРћРЮ ПЙЙц ШАЕПРЛ РЇЧи ЛъКвРќЙЎПЙЙцСјШДы ПюПЕРЛ НУРлЧбДй.
ЛъКвРќЙЎПЙЙцСјШДыДТ 48ИэРЛ МБЙпЧЯПЉ 5Пљ ИЛБюСі ПюПЕЧЯИч, КНУЖ БиНЩЧб АЧСЖБтПЁ ЙпЛ§Чв Мі РжДТ ЛъКв ПЙЙцРЛ РЇЧи АЂЁІ |
|
 [БЄСжЁЄРќГВ] РхШяБК, СЖОч2БИ(ОчАюИЖРЛ) 2021Гт ИЖРЛ ИИЕщБт АјИ№ 4Оя Пј ШЎСЄ |2021. 02.02 [БЄСжЁЄРќГВ] РхШяБК, СЖОч2БИ(ОчАюИЖРЛ) 2021Гт ИЖРЛ ИИЕщБт АјИ№ 4Оя Пј ШЎСЄ |2021. 02.02
[РхШя/CTN]РЬНТШЃ БтРк = РхШяБК РхЕПИщ СЖОч2БИ(ОчАюИЖРЛ)ДТ СіГДо 29РЯ '2021Гт ИЖРЛ ИИЕщБт ЛчОї'ПЁ АјИ№ЧЯПЉ УжСО ШЎСЄЕЦДй.
'2021Гт ИЖРЛ ИИЕщБт ЛчОї'РК СжЙЮ ТќПЉИІ ХыЧб СжЙЮ СжЕЕЧќ ЛѓЧтНФ АјИ№ ЛчОїРИЗЮ, ЧрСЄАњ ИЖРЛ СжЙЮРЧ ЧљОїРЛ ХыЧи ИЖРЛ ЙпРќ ЙцЧтРЛ ШЎИГЧи АЁДТ АЭПЁ СжОШСЁРЛ ЕЮАэ РжДй.
Уб ЛчОїКёДТ 4Оя ПјРИЗЮ 202ЁІ |
|
[УцКЯ] УцКЯГѓБтПј ПЭРЮПЌБИМв, 'ХфТј ШПИ№ БеСж' ЦЏЧу ЕюЗЯ |2021. 02.02 [УцКЯ] УцКЯГѓБтПј ПЭРЮПЌБИМв, 'ХфТј ШПИ№ БеСж' ЦЏЧу ЕюЗЯ |2021. 02.02
[УцКЯ/CTN]ЙкУЖПь БтРк= УцУЛКЯЕЕГѓОїБтМњПј(ПјРх МлПыМЗ) ПЭРЮПЌБИМвДТ БЙЛъ ЦїЕЕИІ РЬПыЧб ПЭРЮЛ§ЛъПЁ ЦЏШЕШ ШПИ№ БеСжРЧ ПЌБИ АГЙпЗЮ ШПРВРЬ ПьМіЧб ШПИ№ИІ МБЙпЧи СіГ 1Пљ ЦЏЧу ЕюЗЯЧпДйАэ ЙрЧћДй.
ПЭРЮПЌБИМвПЁМДТ 2015ГтКЮХЭ 2017ГтБюСі 3ГтАЃ БЙГЛПЁМ РчЙшЕЧДТ ЦїЕЕ ЧАСО РкПЌ ЙпШПОзРИЗЮКЮХЭ ОпЛ§ ШПИ№ БеСж Уб 3,956СОРЛ МіЁІ |
|
 [РЧШИ] ДыРќБЄПЊНУРЧШИ УЄАшМј ПЙАсРЇПјРх, 'ГЊДТКН НАХЭ' РЇЙЎ |2021. 02.02 [РЧШИ] ДыРќБЄПЊНУРЧШИ УЄАшМј ПЙАсРЇПјРх, 'ГЊДТКН НАХЭ' РЇЙЎ |2021. 02.02
[СЄФЁ/CTN]СЄЙЮСи БтРкЄгДыРќБЄПЊНУРЧШИ УЄАшМј ПЙЛъАсЛъРЇПјРх(ДѕКвОюЙЮСжДч, КёЗЪ)РК МГ ИэР§РЛ ИТОЦ 2РЯ АќГЛ МКЦјЗТЧЧЧи КЙСіНУМГРЮ ЁЎГЊДТКННАХЭЁЏИІ УЃОЦ РЇЙЎЧАРЛ РќДоЧпДй.
УЄАшМј РЧПјРК ЁАШћЕч УГСіПЁ РжДТ ОЦЕПЁЄУЛМвГтЕщРЬ ОЦЧФРЛ ФЁРЏЧЯАэ МКРхЧв Мі РжЕЕЗЯ ЧзЛѓ СіПјАњ АќНЩРЛ АЎЕЕЗЯ ЧЯАкДйЁБАэ ИЛЧЯИч, АќАшРкЕщРЧ ГыАэИІ РЇЁІ |
|
 [УцКЯ] УцКЯЕЕ, 2021ГтЕЕ ЧЅСиСі АјНУСіАЁ АсСЄ,АјНУ |2021. 02.02 [УцКЯ] УцКЯЕЕ, 2021ГтЕЕ ЧЅСиСі АјНУСіАЁ АсСЄ,АјНУ |2021. 02.02
[УцКЯ/CTN]ЙкУЖПь БтРк= УцУЛКЯЕЕДТ БнГтЕЕ ЧЅСиСі 27,523ЧЪСі(РќБЙ ЧЅСиСі 52ИИЧЪСіРЧ 5.3%)ПЁ ДыЧб РћСЄАЁАнРЬ СіГ 2Пљ 1РЯРкЗЮ АсСЄ․АјНУ ЕЧОњДйАэ ЙрЧћДй.
СіАЁ ЛѓНТЗќРК 8.25%ЗЮ СіГ Чи(3.78%)КИДй 4.47% ЛѓНТЧб МіФЁРЬИч БнГтЕЕ РќБЙ ЦђБе ЛѓНТЗќ(10.39%) КИДй 2.14% ГЗОвДй.
НУ․БККА КЏЕПЗќРЛ ЛьЦьКИИщ УЛСжНУ ЁІ |
|
 [БЄСжЁЄРќГВ] РхШяБК, ИТУуЧќ РчГСіПјБн СіБо |2021. 02.02 [БЄСжЁЄРќГВ] РхШяБК, ИТУуЧќ РчГСіПјБн СіБо |2021. 02.02
[РхШя/CTN]РЬНТШЃ БтРк = РхШяБК(БКМі СЄСОМј)РК ФкЗЮГЊ19ЗЮ РЮЧи ГЧзРЛ АоАэ РжДТ АќГЛ МвЛѓАјРЮ ЕюПЁ ДыЧи РгДыЗс, ЙшДо МіМіЗс Ею ИТУуЧќ РчГСіПјБнРЛ СіБоЧбДй.
РќММ ЙіНК, ШЙАТї Ею ПюМіОїУМПЭ ПЙНФРх, РхЗЪНФРх Ею ДйСпРЬПыНУМГПЁ ДыЧиМЕЕ ИТУуЧќ РчГСіПјБнРЛ МБКА СіБоЧв АшШЙРЬДй.
ИТУуЧќ РчГСіПјБнРК ЛчШИРћ АХИЎЕЮБт ЙзЁІ |
|
 2026.03.06(Бн) 01:15
2026.03.06(Бн) 01:15

 2026.03.06(Бн) 01:15
2026.03.06(Бн) 01:15
